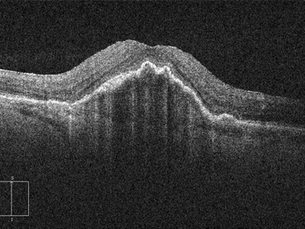
Vascularized Pigment Epithelial Detachment

top of page
Ara


Prepapillary vascular loop
Congenital vascular anomalies of the retina


Macular Macrovessel
Congenital vascular anomalies of the retina


BALAD
Bacillary layer detachment, extensive changes in structure of the retina


Type 2 Neovascularisation
Type 2 neovascularisation in armd


Retinal Angiomatous Proliferation (RAP)
neovascularisation in the retina, armd


Peripapillary Choroidal Neovascularisation
Choroidal neovascularisation originating from the peripapillary region


Subfoveal Choroidal Neovascular Membrane
Armd with choroidal neovascularisation underneath the fovea.


Juxtafoveal Chorodial Neovascular Membrane
Choroidal neovascularisation adjacent to foveal region


Extramacular Choroidal Neovascular Membrane
Armd, choroidal neovascularisation far away from the foveal center


Retinal Dipping
A rare finding usually in central serous chroioretinopathy


Type 1 Neovascularisation
Most frequently encountered choroidal neovascularisation type in armd


Idiopathic Polypoidal Choroidal Vasculopathy
A rare subtype of armd, there are more cases diagnosed in recent years.

Vascularized Pigment Epithelial Detachment
May be accepted as precursor findings of choroidal neovascularisation


Vascularized Pigment Epithelial Detachment
Vascularized PED: Bazen de bu hastada olduğu gibi lezyona koroid neovasküler membranın eşlik ettiği çok açık bir bulgu olarak karşımıza...


Fibrovascular Pigment Epithelial Detachment
Fibrovacular Pigment Epithelial Detachment veya Neovascular PED : Burada gördüğümüz PED diğerlerinden farklı özellikler sergiliyor;...


Pigment Epithelial Detachment
Mostly encountered in armd but other etiologies must be considered in differential diagnosis


Retinal Pigment Epithelial Tears
A rare but devastating complication of both the disease itself and treatment in armd.
bottom of page